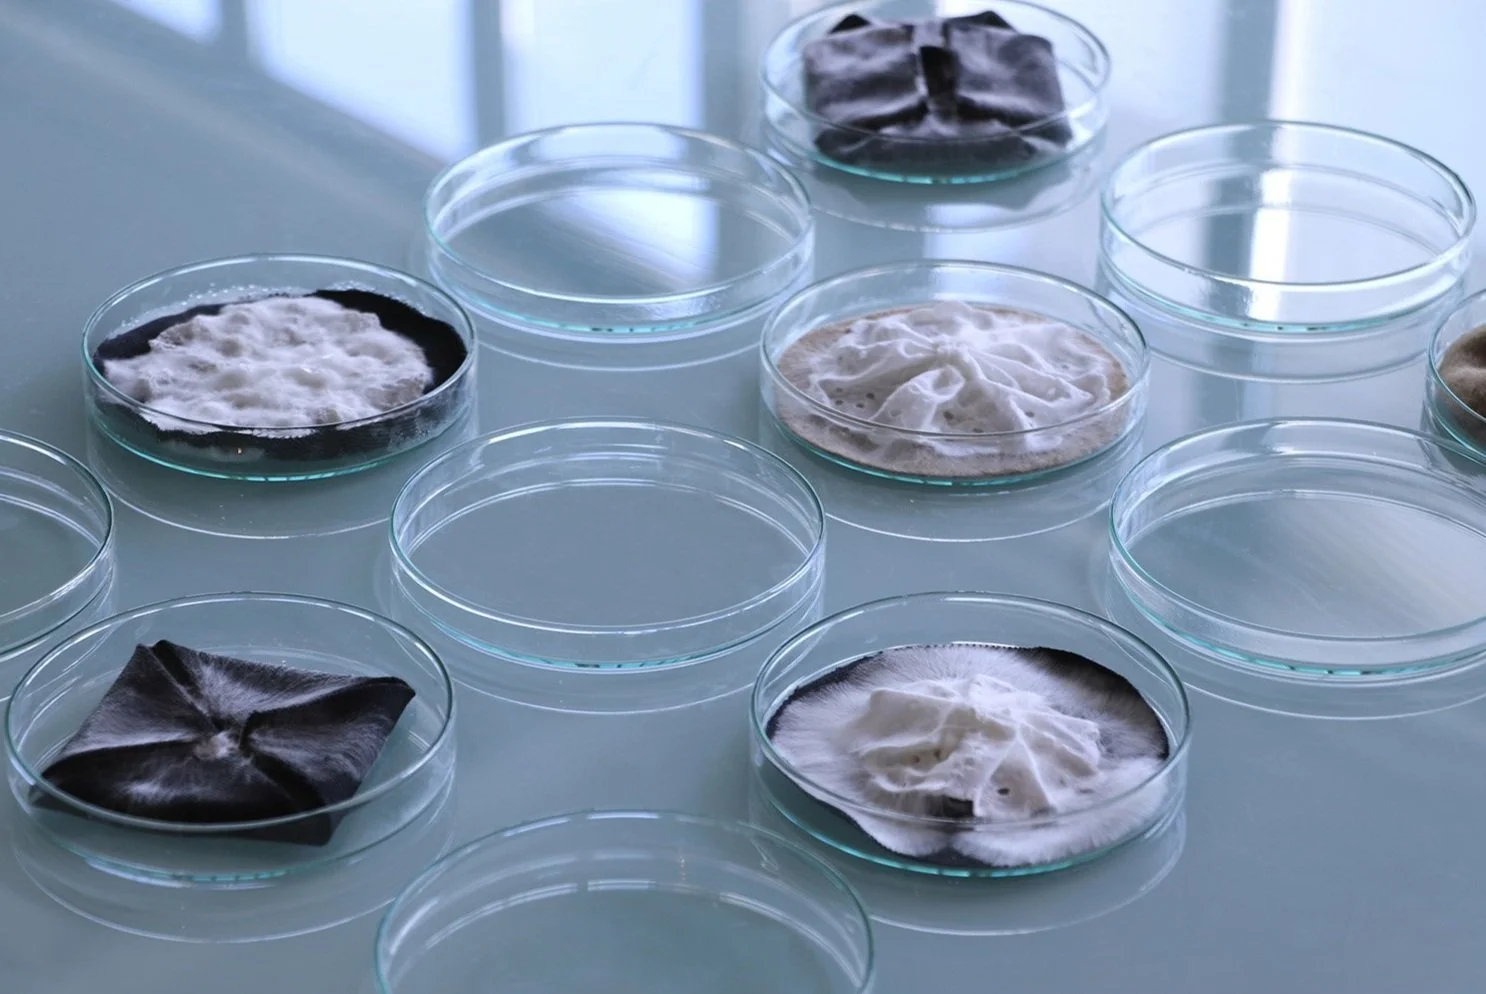

Aléa Work: A Studio Rooted in Change
Exploring the boundary between design, life, and decomposition
Mycelium Chair by Aléa Work
Beneath the surface of the soil, mycelium forms a vast and invisible network—an underground system that connects plants, breaks down organic matter, and helps new life take root. Though often unnoticed, this root-like structure of fungi plays a vital role in keeping ecosystems alive and in balance. Mycelium is both delicate and resilient, spreading slowly through the earth, binding what has fallen apart and nourishing what is yet to grow. Its texture—for some, unfamiliar or even uncanny—is also deeply beautiful, somewhere between lace and roots, part structure, part living organism. It grows, transforms, and eventually disappears—always in motion, always part of something larger than itself.
This quiet, living process lies at the centre of Aléa Work, an experimental design and material research studio based in Paris. Founded in 2021 by Miriam Josi and Stella Lee Prowse, Aléa Work was never intended to follow traditional design pathways. The two met during their Master of Science in Nature-Inspired Design at ENSCI – Les Ateliers, where their shared interest in ecological systems led them to ask a different kind of question: what happens when we allow materials to lead?
Their work resists fixed outcomes. It doesn’t chase perfection or permanence. Instead, Aléa Work pays attention to cycles—growth, decay, transformation—and to the ways design can participate in them without trying to dominate the process. One of their ongoing research projects, Back to Dirt, explores this approach by growing objects directly in soil. Using mycelium and local organic waste, the duo creates structures that form slowly, influenced by the environment around them. There’s no need for sterile conditions, no plastic moulds, no heavy energy use. Just time, matter, and care.
This method shifts the idea of design from a human-centred act to something more shared, more open-ended. In 2021, this approach took shape during a residency at Domaine de Boisbuchet, where Aléa Work grew their first full-scale underground chair. The object was both a result and a record of collaboration—between human intention, fungal behaviour, soil conditions, and chance.
Aléa Work - Studio’s processes - MATTER and SHAPE (2025)
Aléa Work describes this kind of work as bio-inclusive. It’s not just about using biological materials—it’s about entering into a dialogue with them. Rather than treating nature as a resource or a backdrop, their practice involves slowing down, observing, and designing in response to living systems. Their studio moves between design, biology, and agriculture, often ignoring the boundaries between disciplines in favour of exploring what connects them.
In 2023, Aléa Work launched The Garden Lab, a long-term research site at Boisbuchet. There, they continue experimenting with regenerative, place-based practices. The lab is not a pristine space—it’s a living one. Things grow, decay, shift. Designs emerge and sometimes dissolve. It’s a space for learning through making, and for asking what design can become when it’s grounded in land, weather, and more-than-human collaboration.
Their recent work unfolded not in a lab or a field, but on a stage. In September 2024, Aléa Work joined the PLĀS collective for a presentation in Milan—one that looked nothing like a traditional fashion show. There was no runway, no fixed silhouettes, no polished garments demanding permanence. Instead, there were bodies moving slowly through space, each draped in fabric alive with pink Pleurotus fungi. The textiles had been inoculated in advance, cared for, and allowed to grow—becoming something more than costume, yet less than sculpture.
The space itself—developed with set designer Francesco Pizzorusso—felt more like a landscape than a backdrop. The performers, responding to a choreography by Gian Marco Porru, carried the garments with tenderness, as if aware they were wearing something fragile, in process. Directed by Nathalie Danten and captured through the lens of Ludivine Keller, the project invited attention to detail: to textures in transition, to materials that didn’t hide their decay.
Nothing was fixed. Everything was becoming.
This wasn’t an attempt to showcase innovation or spectacle. It was an invitation to consider design as a temporal gesture—something that breathes, changes, and eventually disappears. As with so much of Aléa’s work, the emphasis wasn’t on outcome, but on relationship. Between body and material. Between performer and living fabric. Between the visible and the microscopic.
There were no clear takeaways, no perfected results. Just a series of quiet encounters.
Aléa Work doesn’t position itself as a solution. It operates more like a suggestion, or a pause. A space where design slows down, listens, and lets the material speak in its own time. Like mycelium, it works in layers—often unseen, but always connecting.
And perhaps what matters most isn’t the shape something takes, but the way it moves through the world before it returns to the ground.
'Mycelia' SS25 PLĀS collective - Creative Direction Nathalie Danten - Set design Aléa Work & Francesco Pizzorusso - Choreography by Gian Marco Porru - Photos Ludivine Keller
Their studio operates at the intersection of design, biology, and agriculture, engaging with what they describe as bio-inclusive practices: ways of making that do not dominate or extract from the natural world but instead seek cohabitation and reciprocity.
Aléa Work’s most recent contribution, MYCELIA SS25, brought their vision to textiles and performance. Collaborating with PLĀS collective, creative director Nathalie Danten, and choreographer Gian Marco Porru, they presented garments inoculated with pink Pleurotus fungi during Milan Fashion Week. The project blurred boundaries between fashion and living material, movement and decay—offering a vision of clothing not as a commodity but as a temporal, collaborative ecology.
'Mycelia' SS25 PLĀS collective - Creative Direction Nathalie Danten - Set design Aléa Work & Francesco Pizzorusso - Choreography by Gian Marco Porru - Photos Ludivine Keller
Through their practice, Aléa Work doesn’t offer answers or ready-made solutions. Instead, they nurture questions: What if objects were grown, not made? What if decay was a design principle? And how might we reimagine our relationship with the more-than-human, not as materials users, but as participants in ecosystems of making and unmaking?
Mycelium, after all, is not a metaphor. It is a collaborator. And in the hands of Aléa Work, it becomes a guide for how to design—quietly, radically, and in a relationship.
'Mycelia' SS25 PLĀS collective - Creative Direction Nathalie Danten - Set design Aléa Work & Francesco Pizzorusso - Choreography by Gian Marco Porru - Photos Ludivine Keller
Info
Miriam Josi & Stella Lee Prowse
MYCELIA SS25 Credits
Set design Aléa Work & Francesco Pizzorusso
Creative Direction — Nathalie Danten
Choreography — Gian Marco Porru
Photography — Ludivine Keller
Courtesy
Aléa Work
Words
Nina Zulian